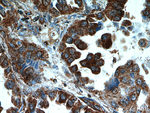
UBAP1 Antibody in Immunohistochemistry (Paraffin) (IHC (P))
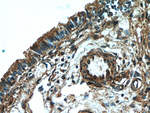
UBAP1 Antibody in Immunohistochemistry (Paraffin) (IHC (P))

Search
Proteintech
UBAP1 Polyclonal Antibody
{{$productOrderCtrl.translations['antibody.pdp.commerceCard.promotion.promotions']}}
{{$productOrderCtrl.translations['antibody.pdp.commerceCard.promotion.viewpromo']}}
{{$productOrderCtrl.translations['antibody.pdp.commerceCard.promotion.promocode']}}: {{promo.promoCode}} {{promo.promoTitle}} {{promo.promoDescription}}. {{$productOrderCtrl.translations['antibody.pdp.commerceCard.promotion.learnmore']}}
产品信息
12385-1-AP
种属反应
已发表种属
宿主/亚型
分类
类型
抗原
偶联物
形式
浓度
规格
纯化类型
保存液
内含物
保存条件
运输条件
产品详细信息
Immunogen sequence: GGSGSVLQD EEVLASLERA TLDFKPLHKP NGFITLPQLG NCEKMSLSSK VSLPPIPAVS NIKSLSFPKL DSDDSNQKTA KLASTFHSTS CLRNGTFQNS LKPSTQSSAS ELNGHHTLGL SALNLDSGTE MPALTSSQMP SLSVLSVCTE ESSPPNTGPT VTPPNFSVSQ VPNMPSCPQA YSELQMLSPS ERQCVETVVN MGYSYECVLR AMKKKGENIE QILDYLFAHG QLCEKGFDPL LVEEALEMHQ CSEEKMMEFL QLMSKFKEMG FELKDIKEVL LLHNNDQDNA LEDLMARAGA S (203-502 aa encoded by BC020950)
靶标信息
Originally named because of its sequence similarity to the Saccharomyces cerevisiae NHP2 (non-histone protein 2), this protein appears to be a highly conserved nuclear protein that is a component of the [U4/U6.U5] tri-snRNP. It binds to the 5' stem-loop of U4 snRNA. Two transcript variants encoding the same protein have been found for this gene.
仅用于科研。不用于诊断过程。未经明确授权不得转售。
生物信息学
蛋白别名: Nasopharyngeal carcinoma-associated gene 20 protein; UAP; UBAP; UBAP-1; UBAP1; Ubiquitin-associated protein 1; unnamed protein product
基因别名: 2700092A01Rik; NAG20; SPG80; UAP; UBAP; UBAP-1; UBAP1
UniProt ID: (Human) Q9NZ09, (Rat) Q5XIS7, (Mouse) Q8BH48
Entrez Gene ID: (Human) 51271, (Rat) 362502, (Mouse) 67123